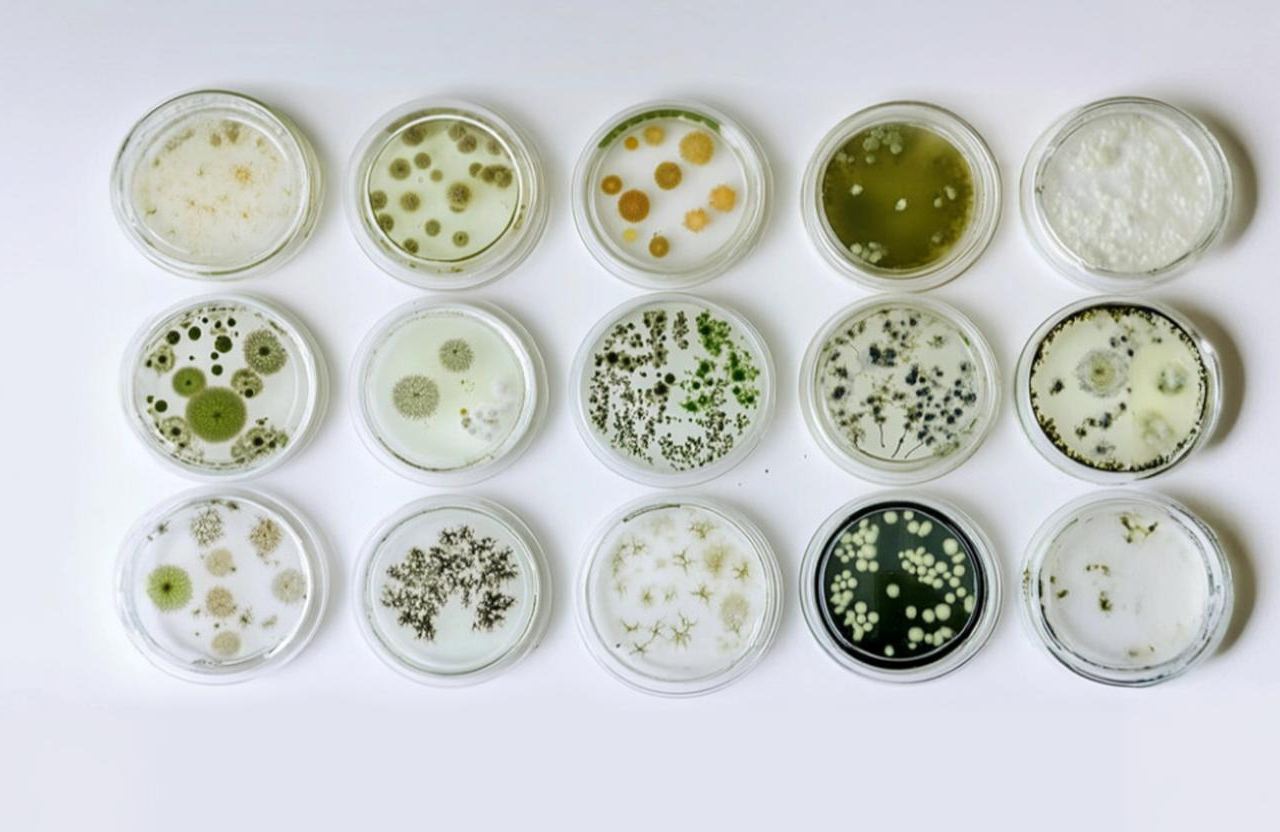
Microbial Identification

Microbial Identification
A microbial identification test is a laboratory procedure used to determine the specific type or species of a microorganism (such as bacteria, fungi, viruses, or protozoa).
Microbial identification testing
Procedures
- Gram staining is a differential staining method used to classify bacteria as Gram-positive or Gram-negative based on their cell wall structure. The procedure involves preparing a smear, heat-fixing it, and applying a series of stains: crystal violet, iodine, decolorizer, and counterstain. Proper technique is crucial to avoid over- or under- decolorization. Microscopic examinations are done under oil immersion, focusing on thin smear areas for accurate results. Modifications of the Gram stain exist for specific clinical applications.
- Biochemical Tests (VITEK, MALDI-TOF)
- VITEK analyzes microbial metabolism via miniaturized biochemical reactions for automated ID.
- MALDI-TOF identifies organisms by ionizing proteins and comparing mass spectra to databases. Both systems provide rapid, high-throughput identification with varying levels of precision.
- 16S rRNA Sequencing (Bacteria): Targets the conserved 16S ribosomal RNA gene using PCR and Sanger or NGS sequencing. Variable regions within the gene allow species-level resolution for most bacteria. Sequences are matched against curated databases (e.g., NCBI, SILVA) for identification.
- 18S rRNA Sequencing (Fungi/Protozoa): Amplifies the conserved 18S rRNA gene to identify eukaryotic microbes like fungi and protozoa. Used when organisms are slow-growing or unculturable using standard methods. Sequence comparison to databases enables genus or species-level identification.
Application
- Medical and Clinical Diagnostics
- Pharmaceutical Industry
- Food and Beverage Industry
- Environmental Monitoring
- Agriculture
- Biotechnology and Industrial Applications
- Forensics and Biosecurity
Reference
Murray, P. R., Rosenthal, K. S., & Pfaller, M. A. (2021). Medical Microbiology (9th ed.). Elsevier. (Specific chapters on bacterial cell structure and microscopic examination). Koneman, E. W., Allen, S. D., Janda, W. M., Procop, G. W., Schreckenberger, F. C., & Woods, G. L. (2017). Koneman's Color Atlas and Textbook of Diagnostic Microbiology (7th ed.). Wolters Kluwer. (Chapters on automated identification systems). Seng, P., Drancourt, M., Gouriet, F., La Scola, B., Fournier, P. E., Rolain, J. M., & Raoult, D. (2009). Ongoing revolution in bacteriology: Matrix-assisted laser desorption ionization–time of flight mass spectrometry (MALDI-TOF MS). Clinical Infectious Diseases, 49(4), 543-551. Woese, C. R., Kandler, O., & Wheelis, M. L. (1990). Towards a natural system of organisms: proposal for the domains Archaea, Bacteria, and Eucarya. Proceedings of the National Academy of Sciences, 87(12), 4576-4579. (Foundational paper for 16S rRNA use in taxonomy). Sogin, M. L., Elwood, H. J., & Gunderson, J. H. (1986). Evolutionary divergence of the eukaryotic small subunit rRNA gene. Proceedings of the National Academy of Sciences, 83(5), 1383-1387. (Foundational paper for eukaryotic rRNA use in taxonomy).